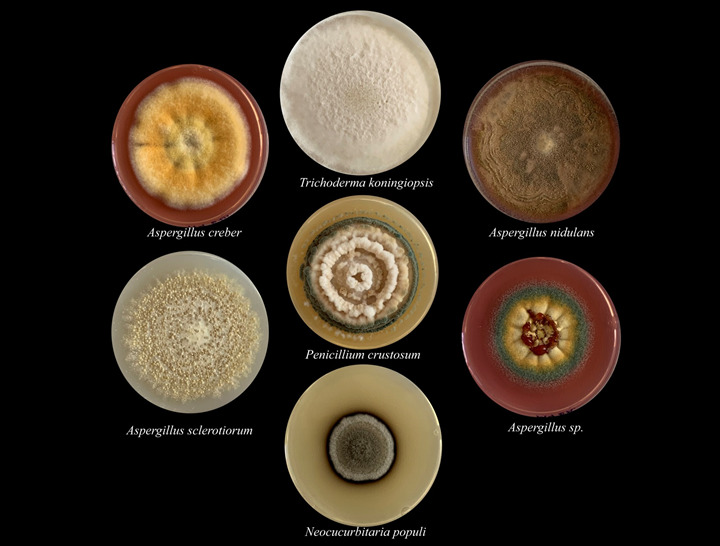
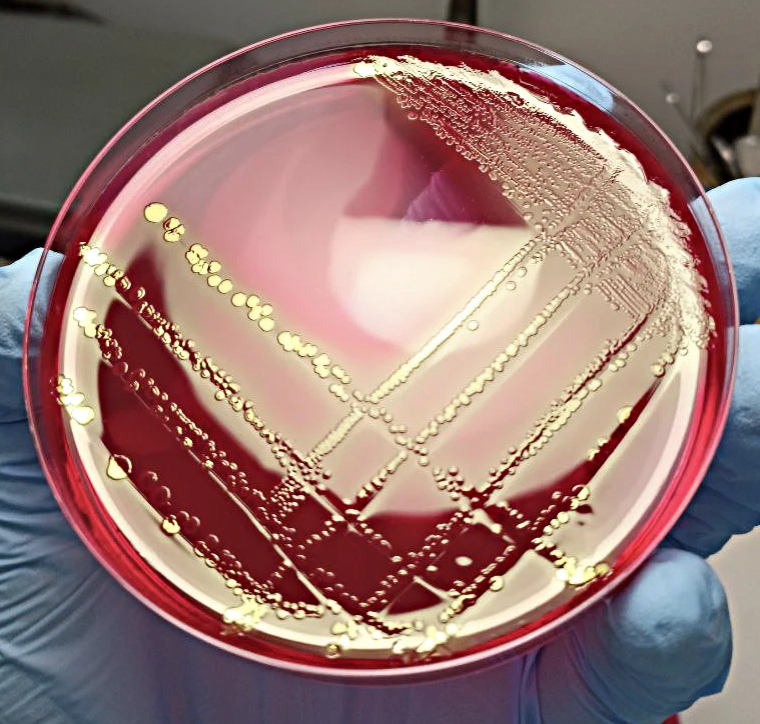

Ко Дню российской науки ФИЦ Биотехнологии РАН провел для сотрудников Центра конкурс научных фотографий «Биотехнология в фокусе» 2026 года.
На Конкурс были представлены фотоработы по трем номинациям, демонстрирующие научную жизнь, лабораторные эксперименты, красоту полевых исследований и научных экспедиций.
Объявляем победителей:
Номинация «Микромир»
1 место — Дарья Авданина, старший научный сотрудник группы генетической инженерии грибов
2 место — Татьяна Жилкина, младший научный сотрудник лаборатории адаптивной фитобиотехнологии
3 место — Ксения Заюлина, научный сотрудник лаборатории метаболизма экстремофильных прокариот
| 1 место Автор: Дарья Авданина |
2 место Автор: Татьяна Жилкина |
3 место Автор: Ксения Заюлина |
![]() |
![]() |
![]() |
Номинация «Магия науки»
1 место — Дарья Басалаева, младший научный сотрудник лаборатории разработки экспрессионных систем
2 место — Евгений Груздев, старший научный сотрудник лаборатории геномики микроорганизмов и метагеномики
3 место — Кристина Демидова, инженер лаборатории разработки экспрессионных систем, и Татьяна Жилкина, младший научный сотрудник лаборатории адаптивной фитобиотехнологии
| 1 место | 2 место | 3 место | |
| Автор: Дарья Басалаева | Автор: Евгений Груздев | Автор: Кристина Демидова | Автор: Татьяна Жилкина |
![]() |
![]() |
![]() |
![]() |
Номинация «Научная вселенная»
1 место — Евгений Груздев, старший научный сотрудник лаборатории геномики микроорганизмов и метагеномики
2 место — Демидова Кристина, инженер лаборатории разработки экспрессионных
3 место — Андрей Летаров, заведующий лабораторией вирусов микроорганизмов
| 1 место Автор: Евгений Груздев |
2 место Автор: Демидова Кристина |
3 место Автор: Андрей Летаров |
![]() |
![]() |
![]() |
Авторы фотографий-призеров будут награждены дипломами и ценными призами.
Торжественное награждение пройдет на Ученом совете ФИЦ Биотехнологии РАН в начале марта.
Поздравляем победителей и благодарим всех сотрудников, принявших участие в конкурсе!